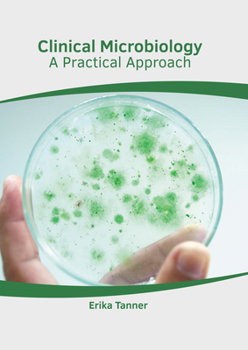
Hardcover Clinical Microbiology: A Practical Approach Book

Clinical Microbiology: A Practical Approach
No Synopsis Available.
Format:Hardcover
Language:English
ISBN:1639272593
ISBN13:9781639272594
Release Date:March 2022
Publisher:American Medical Publishers
Length:241 Pages
Weight:1.75 lbs.
Dimensions:0.6" x 8.0" x 10.9"
Customer Reviews
0 rating